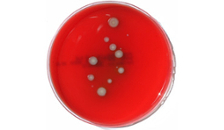

Honey bee diseases
Besides the possible evironmental factors, the researches are focused on the following bee diseases:
- Varroosis
- Nosemosis and Amoebiasis
- Virosis
- Acariosis (tracheal mite)
- American foulbrood
For more information, see the text below and this document (German).